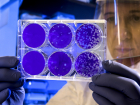
Прокуратура проверяет обоснованность цен на ПЦР-тесты в Краснодаре

ПЦР Новости Блокнот-Краснодара
-
Прокуратура проверяет обоснованность цен на ПЦР-тесты в Краснодаре 11.02.2022 Общество -
Заработали миллиарды: частные клиники Краснодара озолотились за счет тестов на COVID-19 17.09.2021 ЗДОРОВЬЕ -
На Кубани с 1 августа начнут действовать новые правила для туристов 31.07.2021 Общество -
Все идет по плану? Как справляются отели Кубани с новыми антиковидными мерами 30.06.2021 Общество